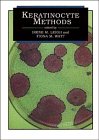
Amazon cover image

Results
|
|
1.
|

Image from Amazon.com
|
District laboratory practice in tropicalcountry by
Edition: Low-price edition.
Material type:  Text Text
Publication details: Cambridge Cambridge University Press 1999
Availability: Items available for loan: Directorate of Library Services (4)Call number: MED REF RB38.C483, ...
|
|
|
2.
|

Image from Amazon.com
|
Statistical methods in biology / by
Edition: 3rd ed.
Material type:  Text Text
Publication details: Cambridge [England] ; New York : 1995. Cambridge University Press, 1995. 1995
Availability: Items available for loan: Directorate of Library Services (2)Call number: MED QH323.5B33, ... Items available for reference: Directorate of Library Services: Not For Loan (1)Call number: MED QH323.5.
|
|
|
3.
|

Image from Amazon.com
|
East African doctors :A history of the modern profession by
Edition: Fountain ed.
Material type:  Text Text
Publication details: Cambridge, United Kingdom : Kampala : Cambridge University Press ; Fountain Publishers, 2002
Availability: Items available for reference: Directorate of Library Services: Not For Loan (1)Call number: MED R149.I44.
|
|
|
4.
|

Image from Amazon.com
|
Communicable disease epidemiology and control : by
Edition: 2nd ed.
Material type:  Text Text
Publication details: Cambridge, MA. : CABI Pub., c2005
Availability: Items available for reference: Directorate of Library Services: Not For Loan (1)Call number: MED RA 643.W37.
|
|
|
5.
|

Image from Amazon.com
|
Biomedical engineering :Bridging medicine and technology by
Edition: 2nd ed.
Material type:  Text Text
Publication details: united kingdom Cambridge university press 2015
Availability: Items available for reference: Directorate of Library Services: Not For Loan (1)Call number: MED R56.S25.
|
|
|
6.
|
|
Clinical virology in oral medicine and dentistry / by
Edition: 1 ed
Material type:  Text Text
Publication details: Cambridge [England] ; New York : Cambridge University Press, 1992
Availability: Items available for reference: Directorate of Library Services: Not For Loan (5)Call number: MED RC815.S4517, ...
|
|
|
7.
|
|
Review of basic science and clinical dentistry by
Edition: 1 ed
Material type:  Text Text
Publication details: Cambridge Harper & Row publisher 1980
Availability: Items available for reference: Directorate of Library Services: Not For Loan (2)Call number: MED RK51.R47, ...
|
|
|
8.
|

Image from Amazon.com
|
Welfare medical care; by
Material type:  Text Text
Publication details: Cambridge, Mass., Harvard University Press, 1970
Availability: Items available for loan: Directorate of Library Services (1).
|
|
|
9.
|

Image from Amazon.com
|
|
|
|
10.
|

Image from Amazon.com
|
|
|
|
11.
|

Image from Amazon.com
|
Poverty and health:a sociological analysis by
Material type:  Text Text
Publication details: London England Cambridge,Massachusetts 1969
Availability: Items available for loan: Directorate of Library Services (2)Call number: MED RA418.P7, ...
|
|
|
12.
|

Image from Amazon.com
|
|
|
|
13.
|

Image from Amazon.com
|
Virus persistence by
Material type:  Text Text
Publication details: New York : Cambridge University Press, 1968
Availability: Items available for loan: Directorate of Library Services (1)Call number: MED RA418.M34.
|
|
|
14.
|

Image from Amazon.com
|
Data-handling in biomedical science / by
Material type:  Text Text
Publication details: Cambridge ; New York : Cambridge University Press, 2010
Availability: Items available for loan: Directorate of Library Services (1)Call number: MED QR69.D35W45.
|
|
|
15.
|

Image from Amazon.com
|
Keratinocyte methods by
Material type:  Text Text
Publication details: New York Cambridge University 1994
Availability: Items available for loan: Directorate of Library Services (7)Call number: MED QP88.5.K44, ...
|
|
|
16.
|

Image from Amazon.com
|
Keratinocyte methods by
Material type:  Text Text
Publication details: New York Cambridge University 1994
Availability: No items available.
|
|
|
17.
|

Image from Amazon.com
|
Keratinocyte methods by
Material type:  Text Text
Publication details: New York Cambridge University 1994
Availability: No items available.
|
|
|
18.
|
Image from Amazon.com
|
Keratinocyte methods by
Material type:  Text Text
Publication details: New York Cambridge University 1994
Availability: No items available.
|
|
|
19.
|

Image from Amazon.com
|
|
|
|
20.
|

Image from Amazon.com
|
|
